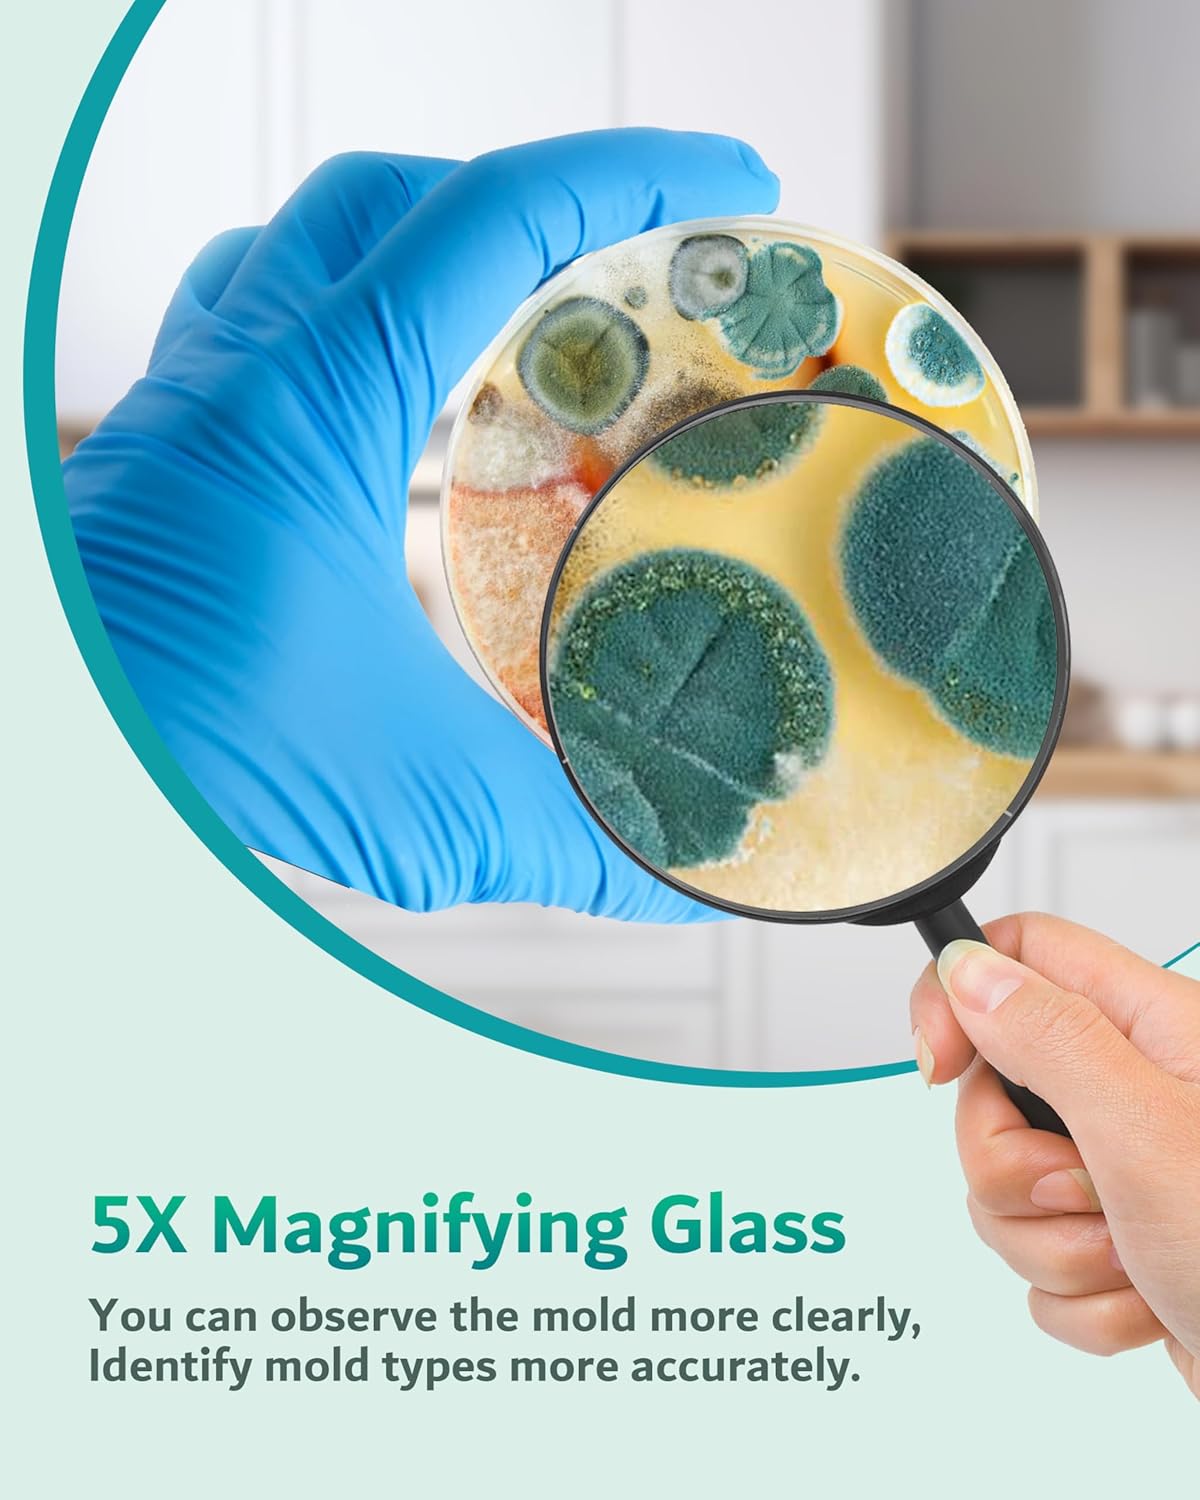

Price: $21.98 - $17.98
(as of Mar 18, 2025 11:59:06 UTC – Details)
From the brand


We love, we create, and we share.
Founded in 2010 by a group of young people with a lot of technical experience, we are committed to providing multiple gadgets for home to make life more convenient and healthy.
With over 15 Years of professional experience, we have acquired the core technologies of microbial detection and culture.


110+ Patents & Certifications
With more than 110 advanced patents and certifications, we have been standing at the forefront of the Biotechnology industry.

100+ Expert Engineers
We have a team of over 120 professional engineers dedicated to the field of formulation research and inspection.
How did we get our start?
In the beginning,We were just a traditional product R&d team.But we gradually discovered that we could do more:Help people in need by sharing our advanced and useful designs.
What makes our products unique?
We pay attention to every customer’s feedback,so we never stop to improve quality and create more new premium products. Because of love,we are more professional.
Why do we love what we do?
We are committed to sharing our useful gadgets to help people in need to make life healthier and more convenient. It’s meaningful and makes us feel that we are valuable.
Product Dimensions : 3.5 x 3.5 x 0.6 inches; 13.44 ounces
Item model number : Mold Testing Kit-010
Date First Available : February 9, 2025
Manufacturer : ENESNES
ASIN : B0DPFS52XM
Country of Origin : China
【𝗪𝗵𝘆 𝗖𝗵𝗼𝗼𝘀𝗲 𝗢𝘂𝗿 𝗠𝗼𝗹𝗱 𝗧𝗲𝘀𝘁 𝗞𝗶𝘁】The rapid proliferation of mold can lead to respiratory issues for many individuals. Our At home mold test kit allows for quick and easy detection of potential mold areas in your house. Once the mold type is identified, you can promptly clear it and maintain a healthy, mold-free living space.
【𝗔𝗹𝗹 𝗬𝗼𝘂 𝗡𝗲𝗲𝗱𝘀 𝗜𝗻𝗰𝗹𝘂𝗱𝗲𝗱】Our best home mold testing kit includes 8 test plates, a 5X magnifying glass(for better visibility), a comprehensive mold guide and removal instructions, enough swabs, label sheets, and test gloves. Everything necessary for effective and thorough mold testing and observation at home included.
【𝟰𝟴𝗵 𝗤𝘂𝗶𝗰𝗸 & 𝗩𝗲𝗿𝘀𝗮𝘁𝗶𝗹𝗲 𝗧𝗲𝘀𝘁𝗶𝗻𝗴】At home mold testing kit can test indoor air, HVAC systems, cars, and various home surfaces like wooden furniture, cabinets, wardrobes, beds, walls, showers, sinks, and more. Detect a wide range of common household molds as fast as 48h-96h. Perfect for teaching, DIY testing, and fun experiments that can help kids develop good habits from an early age.
【𝗙𝗹𝗲𝘅𝗶𝗯𝗹𝗲 𝗧𝗲𝘀𝘁𝗶𝗻𝗴 𝗢𝗽𝘁𝗶𝗼𝗻𝘀】You can perform 8 separate tests or conduct 2 tests in 4 different locations. The test plates are packaged in 2 separate sets, making it convenient for multiple testing sessions and allowing you to retest after mold removal to confirm the success of your cleaning efforts.
【𝗔𝗰𝗰𝘂𝗿𝗮𝘁𝗲 𝗠𝗼𝗹𝗱 𝗜𝗱𝗲𝗻𝘁𝗶𝗳𝗶𝗰𝗮𝘁𝗶𝗼𝗻】Utilize the provided mold guide to determine the type of mold present. If you need assistance, you can send photos to our lab for professional identification, and our expert team will respond within 24 hours(How to send mold photos? Please refer to page 6 of the Mold Guide).Don’t hesitate to reach out to us.
【𝗔𝗶𝗿𝘁𝗶𝗴𝗵𝘁 𝗦𝗮𝗳𝗲 𝗣𝗮𝗰𝗸𝗮𝗴𝗶𝗻𝗴】The AGAR plates are produced in a completely clean workshop and vacuum packed in 3-layer bags after 7 processes to ensure that the product is safe and not contaminated, and you can use it within 2 months after receiving the item without worrying about product safety (please store the unopened plates in a cool place, a small amount of condensation within the completely sealed package is normal and will not affect the product’s performance or usability).
【𝗙𝗿𝗲𝗻𝗱𝗹𝘆 𝗥𝗲𝗺𝗶𝗻𝗱𝗲𝗿】Be sure to open the lid of the petri dish when inoculating the sample, mold growth needs the right temperature, if the temperature is lower than 77 ℉, the sample needs to be cultured for more than 48 hours, so please wait patiently.
【𝗔𝗳𝘁𝗲𝗿-𝘀𝗮𝗹𝗲𝘀 𝗦𝗲𝗿𝘃𝗶𝗰𝗲】Customer’s complete satisfaction is very important to us.Based on “Customer First”concept.For 12 months after the date of purchase,we take care of all quality related issues with a REPLACEMENT or Other Solutions that you are satisfied with. Please feel free to contact us and give us your suggestions.
User Reviews
Be the first to review “Mold Test Kit for Home, 8 Detection Tests for HVAC, Surfaces & Indoor Air Quality, DIY Black Mold Detector Testing kit at Home, Includes Detailed Identification Guide, 5X Magnifier & Free Lab Analysis”
Original price was: $21.98.$17.98Current price is: $17.98.

There are no reviews yet.